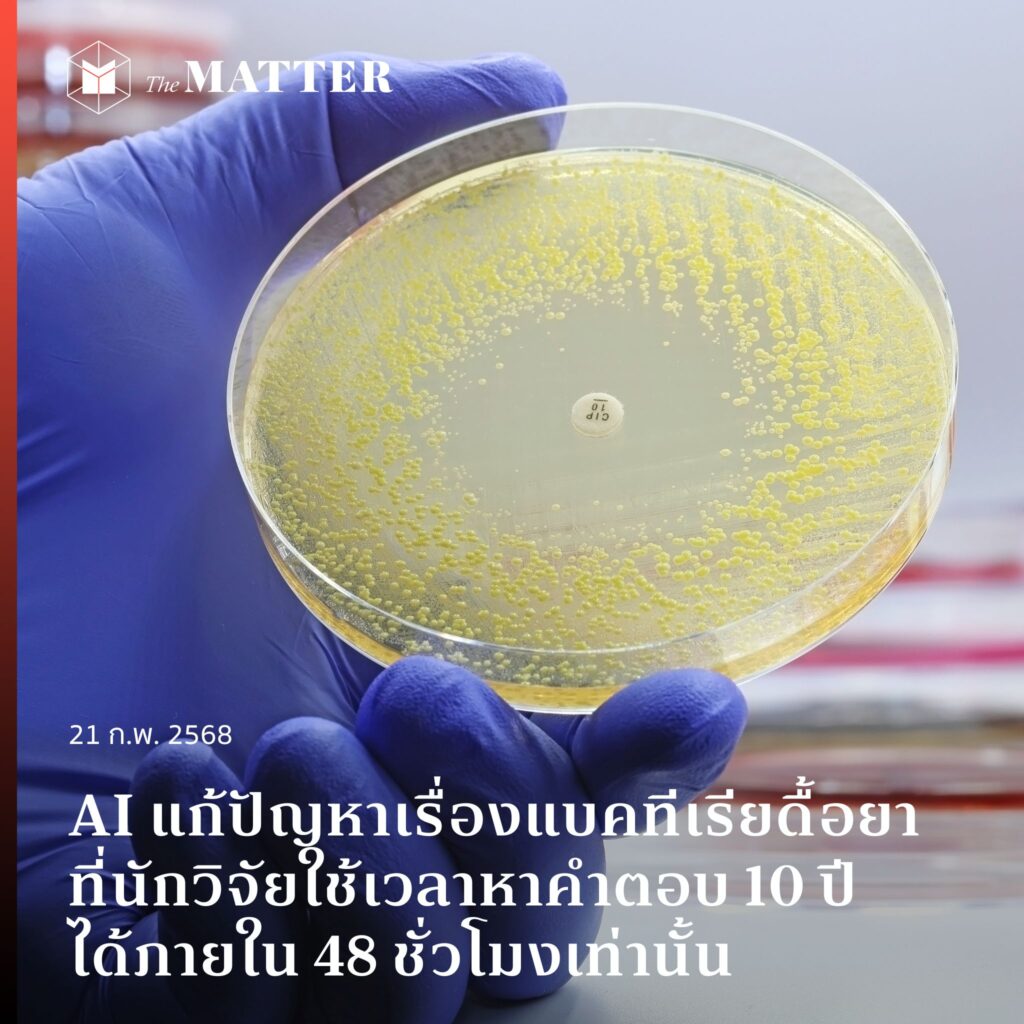

ในวันที่ AI กำลังพัฒนาขึ้นอย่างรวดเร็วและต่อเนื่อง ล่าสุดนี้ มีข่าวที่เกี่ยวข้องกับวงการวิทยาศาสตร์ เมื่อ AI ตอบคำถามที่นักจุลชีววิทยาใช้เวลาหาคำตอบกว่า 10 ปีได้ โดยใช้เวลา 2 วันเท่านั้น (โดยนักวิจัยยังไม่เคยเผยแพร่ข้อมูลนี้ไปยังที่ไหนเลยด้วย)
ศาสตราจารย์ โฮเซ่ อาร์ เปนาเดส (José R Penadés) และทีมงานของเขาที่ Imperial College London ใช้เวลาหลายปีในการหาคำตอบและพิสูจน์ว่าทำไมแบคทีเรียดื้อยาบางชนิดจึงไม่ตอบสนองต่อยาปฏิชีวนะ
เขาลองถามคำถามสั้นๆ นี้ กับ ‘co-scientist’ เครื่องมือปัญญาประดิษฐ์ (AI) ที่ผลิตโดย Google เกี่ยวกับปัญหานี้ที่เขาได้คำตอบแล้ว แต่ยังอยู่ในขั้นตอนพิสูจน์และก็ได้ข้อสรุปเดียวกันภายใน 48 ชั่วโมง
เขาบอกกับสำนักข่าว BBC ว่าเขาตกใจมาก เพราะการวิจัยรวมถึงผลการวิจัยของเขาไม่ได้เผยแพร่ที่ไหนเลย ดังนั้นระบบ AI จึงไม่สามารถค้นหาข้อมูลในโดเมนสาธารณะและนำมาตอบได้แน่นอน เขาถึงกับเขียนอีเมลหา Google ว่าแอบเข้าถึงคอมพิวเตอร์ของเขาหรือเปล่า แต่บริษัทยักษ์ใหญ่ก็ปฏิเสธ
เหล่านักจุลชีววิทยา ระบุว่า ถ้าพวกเขามีสมมติฐานตั้งแต่เริ่มต้นโครงการโดยมีเครื่องมือ AI ช่วยแบบในทุกวันนี้ ก็คงประหยัดเวลาทำงานไปได้หลายปี
ศาสตราจารย์เปนาเดสกล่าวว่าเครื่องมือดังกล่าวไม่เพียงแต่ช่วยจำลองงานวิจัยของเขาได้สำเร็จเท่านั้น แต่ยังให้สมมติฐานอีก 4 ข้อซึ่งล้วนสมเหตุสมผล แถมยังมีบางข้อที่ทีมวิจัยไม่เคยนึกถึงมาก่อน และพวกเขาได้ลองนำสมมติฐานข้อนั้นไปศึกษาต่ออยู่ในขณะนี้
ในงานวิจัย พวกเขาตั้งสมมติฐานว่าเชื้อดื้อยาสามารถสร้างหางได้จากไวรัสต่างชนิดกัน ซึ่งทำให้เชื้อดื้อยาแพร่กระจายระหว่างสายพันธุ์ได้ เปรียบเทียบเหมือนเชื้อดื้อยามีกุญแจ ที่ทำให้มันสามารถเคลื่อนที่จากบ้านหลังหนึ่ง ไปยังบ้านอีกหลังหนึ่งได้ หรือจากสปีชีส์เจ้าบ้านหนึ่งไปยังอีกสปีชีส์เจ้าบ้านหนึ่ง
ที่สำคัญ สมมติฐานนี้เป็นข้อมูลที่ทีมวิจัยและไม่เคยเผยแพร่ที่อื่น ไม่มีใครในทีมแบ่งปันผลการค้นพบของตนกับใครเลย
ดังนั้น เปนาเดสจึงยินดีที่จะใช้สิ่งนี้เพื่อทดสอบเครื่องมือ AI ใหม่ของ Google และเพียง 2 วันต่อมา AI ก็เสนอสมมติฐาน 2-3 ข้อ โดยอันดับต้นๆ แนะนำว่าเชื้อดื้อยาอาจมีหางในลักษณะเดียวกับที่การวิจัยของเขาอธิบายไว้ทุกประการ
แน่นอนว่าปรากฏการณ์นี้ได้สร้างความตื่นเต้น และความตกใจให้กับคนจำนวนมากถึงความก้าวหน้าของเทคโนโลยี และความเป็นไปได้ทางวิทยาศาสตร์ ในขณะที่บางคนก็เริ่มกังวลมากขึ้นว่า AI จะทำให้คนตกงานหรือเปล่า
ศาสตราจารย์เปนาเดสกล่าวว่า เขาเข้าใจดีว่าทำไมความกลัวต่อผลกระทบต่องานของเขาจึงเป็นปฏิกิริยาแรกๆ ที่ผู้คนนึกถึง แต่เขาเสริมด้วยว่า “เมื่อคุณลองคิดดูดีๆ แล้ว คุณจะพบว่าคุณมีเครื่องมือที่มีประสิทธิภาพอย่างยิ่ง”
เขากล่าวว่านักวิจัยในโครงการนี้เชื่อมั่นว่ามันจะมีประโยชน์อย่างมากในอนาคต “ผมรู้สึกว่าสิ่งนี้จะเปลี่ยนแปลงวิทยาศาสตร์อย่างแน่นอน” ศาสตราจารย์เปนาเดสกล่าว
หลายคนอาจจะรู้สึกแล้วว่า AI ได้เข้ามามีบทบาทกับชีวิตประจำวันและในวงการต่างๆ อย่างมาก แต่นี่ถือเป็นอีกก้าวสำคัญที่แสดงถึงวิวัฒนาการสุดล้ำหน้าของ AI ที่อาจพลิกภาพวงการวิจัยไปตลอดกาล
อ้างอิงจาก